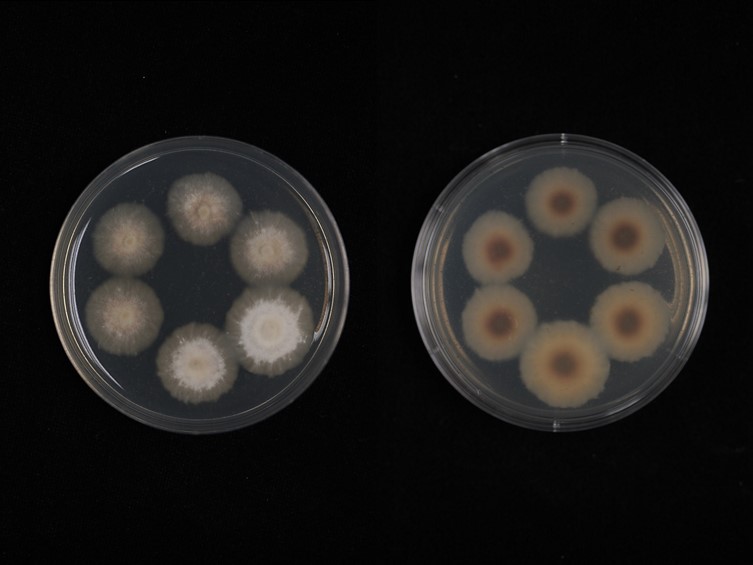

Habitat:
Buried in soil.
Host:
On cicada nymph (Cicadidae: Hemiptera).
Description:

Stroma solitary arising from the dorsal region of the head or the thorax, up to 12 cm long, 2 mm wide. Fertile part, cylindrical to narrowly ovoid, terminal, orange to dark orange. 
Perithecia narrowly ovoid, completely immersed with dense mycelia surrounding each perithecium, 440–590 × 130–300 μm. 
Asci cylindrical, 190–350 × 5–6 μm. 
Ascospores filiform, readily disintegrating into part-spores, 8–11 × 1–2 μm.
Culture characteristics:
Colonies on PDA attaining a diam of 10 mm in 30 d, pale pink, the edge white, hard texture. Conidiogenous cells solitary, ampuliform, smooth-walled, hyaline, with swollen base, and slender top, 10–18 μm long, 2.5–4 μm wide at the swollen base, and 1–2 μm wide at the slender top. Conidia hyaline, ovoid or long oval, solitary, 6.5–10 × 3–4.5 μm.
Species |
Strain |
Compound |
Pubchem CID |
Biological activity |
Reference |
|---|
|
Strain |
- | AB968407 |
|---|---|---|
| EFCC 6814 | EF468817 | - |
| NBRC 108989 | - | AB968421 |